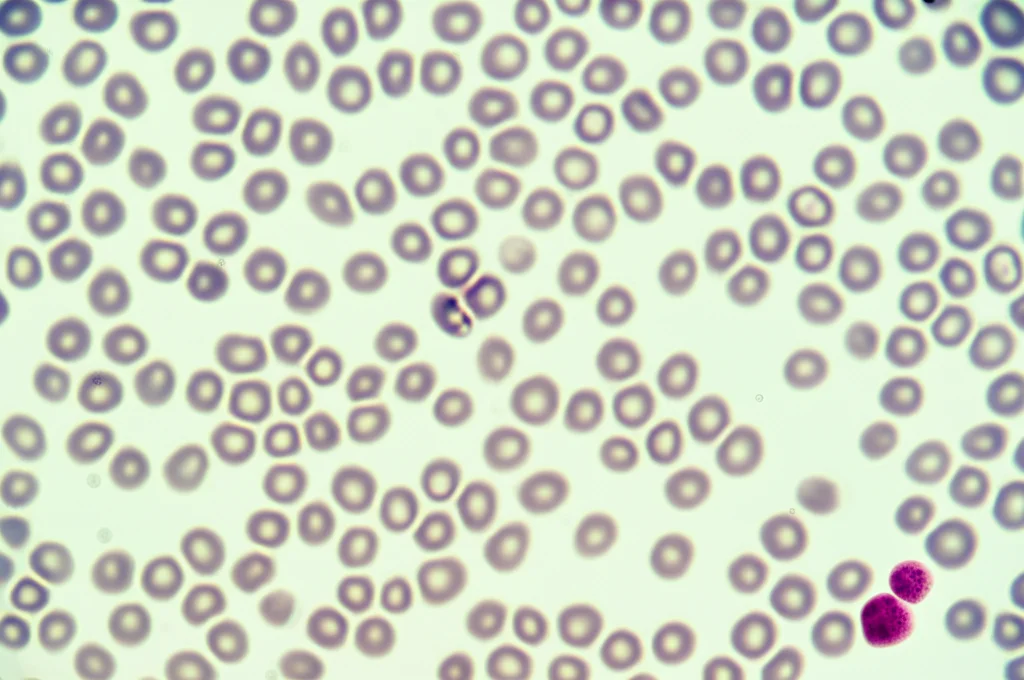
Immagine macro ad alta definizione di una provetta di siero sanguigno in un laboratorio di ricerca, con luce controllata che evidenzia le cellule del sangue, simboleggiando l'analisi della mieloperossidasi. Obiettivo macro 100mm, alta precisione di messa a fuoco.

Parkinson e Infiammazione: Un Enzima nel Sangue Potrebbe Svelare Nuovi Indizi?
Ciao a tutti! Oggi voglio parlarvi di qualcosa di veramente affascinante che sta emergendo nel campo della ricerca sul Parkinson. Sapete, il Parkinson è una di quelle malattie neurodegenerative che ancora ci pongono tante domande, soprattutto riguardo alle sue cause profonde e a come potremmo diagnosticarla prima o seguirne meglio l’evoluzione. E se vi dicessi che un piccolo enzima presente nel nostro sangue potrebbe darci una mano? Parliamo della mieloperossidasi, o MPO.
Cos’è questa Mieloperossidasi (MPO)?
Allora, mettiamola semplice. L’MPO è un enzima che fa parte del nostro sistema immunitario innato, quello che ci difende dagli “invasori” come batteri e altri patogeni. È prodotto principalmente da alcune cellule immunitarie come i neutrofili, i monociti e i macrofagi. Il suo compito è generare sostanze “toste”, come l’ipoclorito (sì, simile alla candeggina, ma in versione biologica!), specie reattive dell’ossigeno e dell’azoto, per uccidere i microbi.
Fin qui tutto bene, no? Il problema sorge quando c’è troppa MPO in giro o quando la sua attività è eccessiva. In questi casi, invece di limitarsi a difenderci, può iniziare a danneggiare i nostri stessi tessuti e cellule, esacerbando l’infiammazione. E indovinate un po’? Livelli elevati di MPO nel sangue sono stati collegati a diverse malattie infiammatorie legate all’età, come:
- Malattie cardiovascolari (coronaropatie, ipertensione)
- Diabete di tipo 2
- Ictus
- Malattia di Alzheimer
- E, appunto, il Parkinson
Si pensa che l’MPO possa essere un legame meccanicistico tra l’infiammazione cronica e il danno tissutale che vediamo in queste condizioni. Nel cervello, ad esempio, l’MPO viene rilasciata dalle cellule gliali (le cellule di supporto dei neuroni) e può contribuire alla patologia legata all’alfa-sinucleina, una proteina chiave nell’insorgenza del Parkinson.
La Nostra Ipotesi: C’entra l’MPO con il Parkinson?
Considerando che l’età, l’infiammazione e la stessa MPO sembrano giocare un ruolo nella patogenesi del Parkinson, ci siamo chiesti: potrebbe esserci un’associazione diretta tra i livelli di MPO nel siero (la parte liquida del sangue) e lo stato della malattia di Parkinson? Già in passato, uno studio aveva mostrato che la concentrazione di MPO nel siero era aumentata nei pazienti con Parkinson e correlava con alcuni parametri misurati tramite DATSCAN (un esame che valuta i trasportatori della dopamina nel cervello).
Inoltre, sappiamo che persone con altre malattie infiammatorie legate all’età, dove la MPO è spesso elevata (come ipertensione, diabete tipo 2, malattie coronariche), hanno un rischio maggiore di sviluppare il Parkinson. Tutti questi indizi puntavano nella stessa direzione. Così, abbiamo deciso di indagare più a fondo, non limitandoci a misurare quanta MPO c’è (la concentrazione), ma anche quanto è “attiva” (l’attività enzimatica).
Cosa Abbiamo Scoperto: Concentrazione vs. Attività
Abbiamo condotto uno studio caso-controllo coinvolgendo 199 partecipanti: 101 persone con diagnosi di Parkinson idiopatico e 98 persone sane come gruppo di controllo, simili per età, sesso e altri fattori demografici. Abbiamo misurato sia la concentrazione che l’attività della MPO nel loro siero.
I risultati sono stati illuminanti! Entrambi i valori, concentrazione e attività della MPO, erano significativamente più alti nei pazienti con Parkinson rispetto ai controlli. Non solo: suddividendo tutti i partecipanti in tre gruppi (terzili) in base ai livelli crescenti di MPO (basso, medio, alto), abbiamo visto che la probabilità di avere il Parkinson aumentava progressivamente passando dal gruppo con MPO bassa a quello con MPO alta. Questo valeva sia per la concentrazione che per l’attività.
Fin qui, sembrava che entrambi i parametri fossero importanti. Ma la vera sorpresa doveva ancora arrivare.
Il Fattore Sorpresa: L’Attività Enzimatica è la Chiave
Quando abbiamo analizzato i dati più in profondità, usando modelli statistici complessi (regressione logistica multivariata) che tenevano conto di molti altri fattori confondenti (come età, sesso, presenza di altre malattie come ipertensione o diabete, uso di farmaci, dose di levodopa assunta dai pazienti), è emerso un quadro più chiaro.
La concentrazione di MPO, una volta considerati tutti questi fattori, non risultava più associata in modo significativo allo stato di Parkinson. In altre parole, sapere solo “quanta” MPO c’era nel sangue non era sufficiente a distinguere chi aveva il Parkinson da chi non lo aveva, una volta “pulito” il dato da altre influenze.
Ma l’attività enzimatica della MPO? Quella sì! È rimasta il fattore più fortemente associato alla presenza di Parkinson (Odds Ratio = 6.921, P = 0.001). Questo significa che, indipendentemente dagli altri fattori, un’elevata attività della MPO nel siero aumentava significativamente le probabilità di avere la malattia. È un risultato potente! Suggerisce che non è solo la quantità di enzima a contare, ma quanto quell’enzima è effettivamente “acceso” e funzionante. L’attività di un enzima, infatti, non dipende solo dalla sua concentrazione, ma anche da meccanismi regolatori fini (come fosforilazioni, modulazioni allosteriche) che ne determinano l’efficienza catalitica.

E la Depressione? Un Legame Inaspettato
Un altro dato interessante emerso dalla nostra analisi riguarda la depressione. Sappiamo che la depressione è comune nel Parkinson e spesso precede i sintomi motori. Nel nostro studio, abbiamo trovato che la depressione era direttamente associata sia a una maggiore attività della MPO nel siero, sia a maggiori probabilità di avere il Parkinson (OR = 0.121, B = -2.108, P = 0.002 – *Nota: l’OR < 1 qui indica che l'assenza di depressione riduce le probabilità, quindi la presenza le aumenta*). Questo rafforza l'idea di un legame tra infiammazione (rappresentata dall'attività MPO), disturbi dell'umore e Parkinson. Non a caso, l'MPO è considerata uno dei fattori pro-infiammatori coinvolti nella cosiddetta "teoria infiammatoria della depressione".
Farmaci Anti-infiammatori e Statine: Un Quadro Complesso
Ci siamo anche chiesti se l’uso di farmaci comuni potesse influenzare questi risultati. Abbiamo osservato che l’uso di statine (farmaci per il colesterolo) e di FANS (farmaci anti-infiammatori non steroidei, come l’ibuprofene) riduceva significativamente l’attività della MPO nel siero. Questo ha senso, dato il loro effetto anti-infiammatorio.
Tuttavia, l’associazione tra l’uso di questi farmaci e una ridotta probabilità di avere il Parkinson non è “sopravvissuta” alle correzioni statistiche per test multipli. Qui la faccenda si complica. Perché farmaci che abbassano l’attività della MPO (che è associata al Parkinson) non sembrano proteggere chiaramente dalla malattia?
Una possibile spiegazione, almeno per le statine, è che potrebbero avere altri effetti potenzialmente dannosi nel contesto del Parkinson (alcuni studi suggeriscono addirittura un aumento del rischio), che annullerebbero il beneficio derivante dalla riduzione dell’attività MPO. Per i FANS, gli studi epidemiologici sull’uomo non hanno finora mostrato un chiaro effetto protettivo contro il Parkinson, nonostante i benefici visti in modelli sperimentali.

Un’Ipotesi Affascinante: Micro-ictus e Infiammazione Periferica?
Ma perché l’attività della MPO nel sangue dovrebbe essere così legata a una malattia che colpisce principalmente il cervello? Qui entriamo nel campo delle ipotesi, ma è stimolante provare a connettere i puntini.
L’MPO, come abbiamo detto, è un marcatore di infiammazione e danno tissutale. Un’elevata attività potrebbe riflettere un’attivazione cronica dei leucociti circolanti. E se questa attivazione fosse legata a piccoli, magari silenziosi, danni vascolari? L’ipotesi che avanziamo è che l’associazione tra attività MPO e Parkinson possa essere legata all’occorrenza di micro-ictus (microinfarti o microemorragie), specialmente nelle regioni nigrostriatali vulnerabili nel Parkinson.
Sappiamo che piccoli infarti cerebrali sono comuni con l’invecchiamento e che la malattia dei piccoli vasi cerebrali è spesso osservata nel Parkinson. Questi micro-danni potrebbero:
- Attivare i leucociti nel sangue (aumentando l’attività MPO).
- Causare danni alla barriera emato-encefalica (la protezione tra sangue e cervello).
- Permettere ai leucociti “iperattivi” e carichi di MPO di infiltrarsi nel cervello vicino alle aree danneggiate, rilasciando sostanze tossiche (come l’ipoclorito) che danneggiano ulteriormente i neuroni dopaminergici.
Questa ipotesi si collegherebbe anche alla teoria dell’inizio periferico del Parkinson, secondo cui il processo patologico potrebbe iniziare nell’intestino. Micro-danni vascolari a livello intestinale potrebbero innescare l’attivazione dei leucociti e l’infiammazione locale, contribuendo alla formazione di aggregati di alfa-sinucleina che poi si diffonderebbero al cervello.
Cosa Significa Tutto Questo?
In sintesi, il nostro studio suggerisce che l’attività dell’enzima MPO nel siero è un marcatore indipendente associato alla malattia di Parkinson. Mentre anche la concentrazione è aumentata, è l’attività che sembra avere il legame più forte e robusto con la malattia, resistendo anche quando si considerano molti altri fattori.
Questo potrebbe avere implicazioni importanti per la valutazione del Parkinson in futuro. L’attività della MPO potrebbe diventare un biomarcatore utile? È presto per dirlo, ma apre una strada interessante. Inoltre, rafforza l’idea che l’infiammazione sistemica e forse anche piccoli eventi vascolari giochino un ruolo significativo nella complessa partita del Parkinson.

Limiti e Prossimi Passi
Ovviamente, ogni studio ha i suoi limiti. Il nostro è uno studio trasversale, quindi non possiamo stabilire un rapporto di causa-effetto, ma solo un’associazione. Serviranno studi più ampi e longitudinali (che seguono i pazienti nel tempo) per confermare questi risultati e capire meglio il ruolo prognostico dell’attività MPO. Dobbiamo anche considerare la potenziale influenza dei farmaci dopaminergici (anche se abbiamo cercato di tenerne conto) e possibili variazioni giornaliere dei livelli di MPO.
Tuttavia, i punti di forza ci sono: abbiamo studiato pazienti e controlli ben caratterizzati, raccolto dati in modo rigoroso e usato analisi statistiche robuste.
La ricerca non si ferma qui. Questi risultati ci spingono a esplorare ulteriormente il ruolo dell’MPO e dell’infiammazione nel Parkinson, sperando di trovare nuove strategie per la diagnosi precoce e, perché no, per futuri trattamenti mirati.
Fonte: Springer







